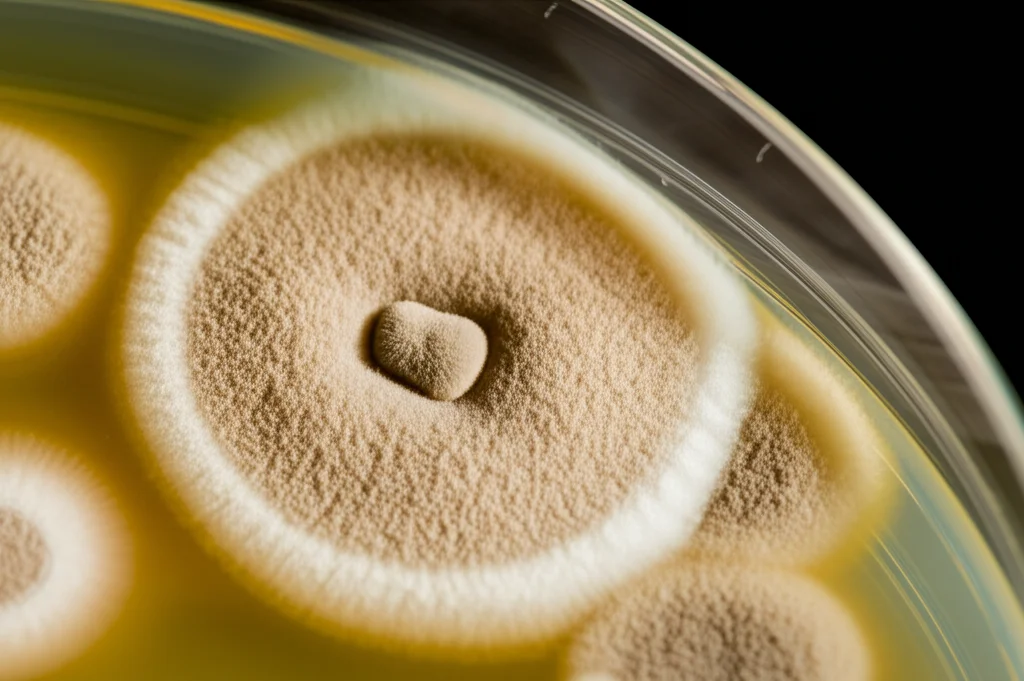
Macro fotografia di colonie fungine di Aspergillus su una piastra di Petri in laboratorio, illuminazione laterale controllata per evidenziare la texture, messa a fuoco estremamente precisa sulle strutture filamentose, obiettivo macro 100mm, alta definizione.

Aspergillosi Invasiva: Sicuri che la Neutropenia Sia Ancora il Cattivo Principale?
Ciao a tutti! Oggi voglio parlarvi di un argomento che, da appassionato di medicina e delle sue evoluzioni, mi intriga parecchio: l’aspergillosi invasiva (IA). Per anni, abbiamo associato questa brutta infezione fungina quasi esclusivamente a una condizione specifica: la neutropenia, ovvero quando i neutrofili, un tipo di globuli bianchi fondamentali per combattere le infezioni, scendono sotto un certo livello. Era quasi un dogma: paziente neutropenico? Occhio all’Aspergillus!
Ma siamo sicuri che sia ancora così? Il mondo della medicina cambia, le terapie evolvono, e con esse anche i “nemici” che dobbiamo affrontare, o meglio, i pazienti che diventano più vulnerabili. Recentemente mi sono imbattuto in uno studio retrospettivo molto interessante condotto all’Ospedale Universitario Puerta de Hierro-Majadahonda, vicino Madrid, che ha analizzato i casi di IA tra il 2018 e l’aprile 2024. E i risultati, lasciatemelo dire, fanno riflettere.
La Sorpresa: La Neutropenia non è più la Regina Indiscussa
Pensate un po’: su 112 casi di aspergillosi invasiva identificati in questo ospedale universitario all’avanguardia (con trapianti d’organo solido, trapianti di midollo, terapie CAR-T, oncologia, varie terapie intensive…), solo 11 pazienti (appena il 9.8%!) avevano la neutropenia come fattore di rischio principale al momento della diagnosi o nel mese precedente. Undici su centododici! Questo dato da solo mi ha fatto drizzare le antenne.
Allora, chi sono i nuovi “bersagli” preferiti dell’Aspergillus? Lo studio ce lo dice chiaramente:
- Uso di corticosteroidi: ben il 77.2% dei pazienti li assumeva. Sappiamo che gli steroidi, pur essendo farmaci salvavita in molte condizioni, abbassano le difese immunitarie.
- Trapianto di organo solido (SOT): il 46.5%, specialmente trapianti di polmone.
- Infezione da SARS-CoV-2: quasi il 30% dei casi. La pandemia ci ha lasciato anche questa eredità, un polmone danneggiato dal virus sembra essere un terreno fertile per l’Aspergillus.
- Replicazione del Citomegalovirus (CMV): circa il 29%. Anche il CMV è noto per scombussolare il sistema immunitario, specialmente nei pazienti già fragili.
Certo, c’erano anche pazienti con malattie ematologiche (quasi il 20%) o oncologiche (8%), ma la stragrande maggioranza dei casi si verificava in pazienti non neutropenici. È un cambiamento di paradigma notevole!
Presentazioni Diverse: Neutropenici vs Non-Neutropenici
Un altro aspetto affascinante emerso dallo studio sono le differenze nel modo in cui l’IA si manifesta nei due gruppi. Sembra quasi che l’Aspergillus si comporti diversamente a seconda del “terreno” che trova.
Nei pazienti neutropenici, la presentazione è più “classica”, se così possiamo dire:
- È più probabile trovare il famoso “segno dell’alone” (halo sign) nelle TAC polmonari (45.5% vs 7.4% nei non-neutropenici). Questo segno indica angioinvasione, cioè il fungo che invade i vasi sanguigni, cosa più facile quando mancano i neutrofili a contrastarlo.
- È più frequente avere il test del galattomannano (GM) positivo nel siero (45.5% vs 25.7% nei non-neutropenici, anche se la differenza non era statisticamente significativa con le correzioni applicate, c’è un trend). Il GM è un componente della parete cellulare del fungo, e trovarlo nel sangue suggerisce un’invasione più profonda.
- Le colture fungine da campioni respiratori sono meno frequentemente positive (54.5% vs 83.2% nei non-neutropenici).
Nei pazienti non-neutropenici, invece, il quadro è più sfumato e variegato:
- I reperti radiologici alla TAC sono più eterogenei: meno “halo sign”, ma magari più opacità a vetro smerigliato, micronoduli, aspetto ad “albero in fiore” (tree-in-bud).
- Le colture da campioni respiratori (come il lavaggio broncoalveolare, BAL) sono molto più spesso positive (oltre l’83%).
- Il GM nel BAL tende ad essere positivo più frequentemente (81.3% vs 66.7% nei neutropenici, anche qui un trend non statisticamente significativo). Questo suggerisce una predominanza della fase bronco-invasiva rispetto a quella angio-invasiva.
- Purtroppo, in questo gruppo sono stati osservati anche casi di infezione disseminata (6 casi, 5.4%), cosa non vista nei pazienti neutropenici dello studio. Questo potrebbe essere legato a una diagnosi più tardiva, data la presentazione meno specifica? È una domanda aperta.

La Famiglia Aspergillus si Allarga (e Diventa più Tosta)
Parliamo ora del fungo stesso. L’Aspergillus fumigatus resta il “capofamiglia”, responsabile di circa la metà dei casi (51.6%) in cui è stato identificato. Ma attenzione, perché stanno emergendo altri membri della famiglia, e alcuni sono particolarmente ostici.
Lo studio ha identificato ben il 14% di casi causati da quelle che vengono chiamate specie criptiche di Aspergillus (come A. lentulus, Neosartorya udagawae, A. hortai…). Perché “criptiche”? Perché sono morfologicamente simili a quelle più comuni ma geneticamente diverse, e spesso hanno profili di resistenza agli antifungini intrinsecamente più alti. E infatti, tra le specie criptiche della famiglia Fumigati isolate nello studio, la resistenza a farmaci come Voriconazolo, Isavuconazolo e Amfotericina B era significativamente più alta rispetto all’A. fumigatus sensu stricto (cioè quello “classico”).
Ma non è finita qui. Anche l’A. fumigatus “classico” sta iniziando a sviluppare resistenze acquisite, soprattutto agli azoli (una classe importante di antifungini). Nello studio, sono stati trovati 2 isolati resistenti a Voriconazolo/Isavuconazolo e uno resistente a Posaconazolo/Itraconazolo/Amfotericina B. Uno di questi presentava la famosa mutazione TR34-L98H, un meccanismo di resistenza agli azoli che sta diventando preoccupante in diverse parti del mondo, anche se sembrava meno comune in Spagna fino a poco tempo fa.
Questa resistenza è particolarmente rilevante nei casi di “breakthrough IFI” (Infezione Fungina Invasiva che si sviluppa nonostante una profilassi antifungina in corso). Nello studio, oltre un terzo dei casi (36.6%) erano breakthrough, e in più della metà di questi (51.2%), l’isolato di Aspergillus era resistente al farmaco che il paziente stava assumendo come profilassi! Questo succede spesso, ad esempio, nei trapiantati di polmone che fanno profilassi con Amfotericina B nebulizzata (che favorisce l’emergere di specie diverse da A. fumigatus) o nei pazienti ematologici in profilassi con Posaconazolo. È un circolo vizioso: usiamo farmaci per prevenire, ma questo può selezionare ceppi resistenti.
Diagnosi e Terapia: Un Puzzle Complesso
Tutto questo ci porta a delle riflessioni importanti sulla diagnosi e la terapia. Se i pazienti a rischio non sono più solo i neutropenici, e se le presentazioni cliniche e radiologiche sono diverse, dobbiamo adattare il nostro approccio.
Nei non-neutropenici, dove i sintomi possono essere più subdoli e i test sierologici meno affidabili (tranne forse nei casi associati a influenza, IAPA), diventa cruciale ottenere campioni respiratori per coltura e test del GM su BAL. La broncoscopia gioca quindi un ruolo fondamentale. Al contrario, nei neutropenici, i biomarker sierologici e forse le PCR specifiche per Aspergillus potrebbero avere un peso maggiore, insieme all’imaging che cerca quei segni più “tipici” come l’alone.
Lo studio suggerisce persino un possibile algoritmo diagnostico differenziato (mostrato nella Figura 4 del loro articolo) a seconda della presenza o assenza di neutropenia. E sottolinea anche il potenziale ruolo della PET-CT con 18F-FDG, una metodica di imaging funzionale che potrebbe aiutare a scovare lesioni “nascoste” e a stadiare meglio la malattia, specialmente nei casi dubbi o disseminati. Noi stessi, come gruppo di ricerca, stiamo studiando attivamente l’utilità della PET-CT nelle infezioni fungine e speriamo di avere presto dati più solidi da uno studio multicentrico in corso (NCT05688592).

E la terapia? La scelta dell’antifungino diventa più complessa. Se sospetto una specie criptica o una resistenza agli azoli, magari perché il paziente è in profilassi o proviene da un’area ad alta prevalenza di resistenza, dovrò considerare farmaci diversi fin dall’inizio. Nello studio, si nota come nei neutropenici si tendesse a usare più Amfotericina B liposomiale (L-AmB), mentre nei non-neutropenici si preferiva l’Isavuconazolo o il Voriconazolo. Ma la crescente resistenza, soprattutto nei casi breakthrough, ci dice che dobbiamo assolutamente avere dati di sensibilità del fungo isolato il prima possibile per ottimizzare la terapia. Tecniche rapide come il MALDI-TOF per identificare la specie e le PCR per cercare mutazioni di resistenza note possono essere di grande aiuto.
Cosa Portiamo a Casa?
Questo studio, pur essendo retrospettivo e di un singolo centro, ci lancia un messaggio forte: il panorama dell’aspergillosi invasiva sta cambiando.
- La neutropenia non è più il fattore di rischio predominante. Dobbiamo avere un alto indice di sospetto anche in pazienti non neutropenici con altri fattori di rischio (steroidi, trapianti, COVID, CMV, terapie mirate…).
- La presentazione clinica, radiologica e microbiologica differisce tra pazienti neutropenici e non-neutropenici, richiedendo approcci diagnostici mirati.
- L’emergenza di specie criptiche e la crescente resistenza agli antifungini (sia intrinseca che acquisita, anche nell’A. fumigatus) sono sfide reali che complicano la terapia.
- La mortalità per IA rimane purtroppo alta (nello studio era del 33.9% in ospedale), sottolineando la necessità di diagnosi precoci e trattamenti efficaci e mirati.
Insomma, l’Aspergillus è un fungo opportunista che sa adattarsi e colpire dove le nostre difese sono più deboli, e queste debolezze oggi non sono più legate solo alla mancanza di neutrofili. È fondamentale che noi clinici teniamo il passo con questi cambiamenti per non farci trovare impreparati. La guardia deve restare alta, e la ricerca deve continuare a fornirci strumenti diagnostici e terapeutici sempre più efficaci.
Fonte: Springer
